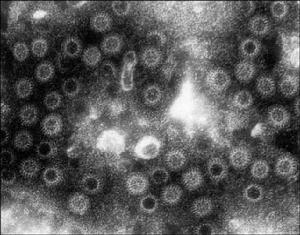
擬態弧菌腸炎

擬態弧菌
 擬態弧菌腸炎
擬態弧菌腸炎檢驗方法
擬態弧菌腸炎
擬態弧菌腸炎增菌↓37℃8-16h
取10mL加入雙倍APW
↓37℃6-8h
選擇選擇培養基tcbs
(霍利斯用非選擇性的羊血球瓊脂)
↓37℃24h
定弧菌取黃色或綠色菌落做G染色、氧化酶、動力、
↓O/129(150ug)、D-甘露糖
分組初步鑑定:0%NacL,1%NacL、硝酸鹽還原、精氨酸雙水解酶、賴氨酸脫羧、鳥氨酸脫羧、(氧化酶)
分成5組
↓
確證最後鑑定。
治療
 擬態弧菌腸炎
擬態弧菌腸炎①病原治療。病毒性腸炎一般不需病原治療,可自愈。腸毒素性細菌性腸炎一般也不套用抗菌藥。侵襲性細菌性腸炎,最好根據細菌藥物敏感試驗結果選用抗菌藥。患細菌性痢疾時,因痢疾桿菌對常用抗菌藥廣泛耐藥,一般可選用複方磺胺甲基異唑(複方新諾明)、吡哌酸、慶大黴素、丁胺卡那黴素等。空腸彎曲菌腸炎可用紅黴素、慶大黴素、氯黴素等治療。耶爾森氏小腸結腸炎桿菌腸炎一般套用慶大黴素、卡那黴素、複方磺胺甲基異唑、四環素、氯黴素等。沙門氏菌腸炎輕型病人可不用抗菌藥,重型病人可用氯黴素或複方磺胺甲基異唑。侵襲性大腸桿菌性腸炎用新黴素、粘菌素和慶大黴素等治療,可獲良好效果。阿米巴痢疾、雅爾氏鞭毛蟲和滴蟲引起的腸炎,可用甲硝噠唑(滅滴靈)治療。血吸蟲病可用吡喹酮治療。白色念珠菌腸炎以制黴菌素口服,療效較好。伴有全身性真菌感染者,則需套用二性黴素B治療。
②補充液體及糾正電解質和酸中毒。輕度脫水而且嘔吐不重者,可口服補液,WHO推薦的口服液配方為氯化鈉3.5g,碳酸氫鈉2.5g,氯化鉀1.5g,葡萄糖20g或蔗糖40g,加水1000ml。脫水或嘔吐較重者,可靜脈輸入生理鹽水、等滲碳酸氫鈉和氯化鉀溶液以及葡萄糖。
③減少腸道蠕動和分泌性藥物。可小量套用阿托品、顛茄、普魯本辛以減輕腸道蠕動,可止痛及止瀉。也可套用氯丙嗪,有鎮靜作用,並可抑制腸毒素引起的腸黏膜過度分泌,使大便次數及便量減少。
